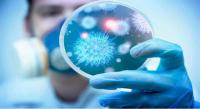

-
 أخبار عالميّة
02 ماي 2020 (00:25)
أخبار عالميّة
02 ماي 2020 (00:25)
تراجع بنسبة 70 بالمائة: تعطيل المطارات يحرم أطفال العالم من اللقاحات الروتينيّة
-
 أخبار عالميّة
01 ماي 2020 (23:25)
أخبار عالميّة
01 ماي 2020 (23:25)
مرض "كاواساكي" يلفت انتباه اطباء العالم: التهاب يصيب الأوعية الدموية والقلب قد يكون قاتلا للأطفال
-
 أخبار عالميّة
01 ماي 2020 (13:28)
أخبار عالميّة
01 ماي 2020 (13:28)
ترامب يعلق على فيديوهات الأطباق الطائرة التي نشرها البنتاغون
-
 أخبار عالميّة
01 ماي 2020 (13:25)
أخبار عالميّة
01 ماي 2020 (13:25)
فرنسا تسجل أعلى نسبة وفيات في العالم بفيروس كورونا
-
 أخبار عالميّة
01 ماي 2020 (13:24)
أخبار عالميّة
01 ماي 2020 (13:24)
منظمة الصحة العالمية: موجة ثانية قادمة لفيروس كورونا لا مفر منها، والعالم لن يتمكن من تفادي هذا السيناريو
-
 أخبار عالميّة
01 ماي 2020 (13:05)
أخبار عالميّة
01 ماي 2020 (13:05)
منشق كوري: كيم جونغ أون توفي منذ أسبوع
-
أخبار عالميّة
30 أفريل 2020 (17:22)
أخبار عالميّة
30 أفريل 2020 (17:22)
كورونا.. طبيب إيطالي يفسر سر فحوصات ديبالا الإيجابية
-
 أخبار عالميّة
29 أفريل 2020 (22:17)
أخبار عالميّة
29 أفريل 2020 (22:17)
ارتفاع عدد الوفيات في بريطانيا إلى 26097 حالة بعد إضافة 4419 حالة سجلت خارج المستشفيات
-
 أخبار عالميّة
29 أفريل 2020 (16:34)
أخبار عالميّة
29 أفريل 2020 (16:34)
بعد تعافيه من كورونا.. بوريس جونسون يرزق بمولود جديد من خطيبته التي تصغره بأكثر من ربع قرن
-
 أخبار عالميّة
29 أفريل 2020 (00:07)
أخبار عالميّة
29 أفريل 2020 (00:07)
مسؤول صحي روسي: العالم سيواجه وباء أكثر فتكا من جائحة فيروس كورونا وهذه الأماكن الأكثر خطورة










